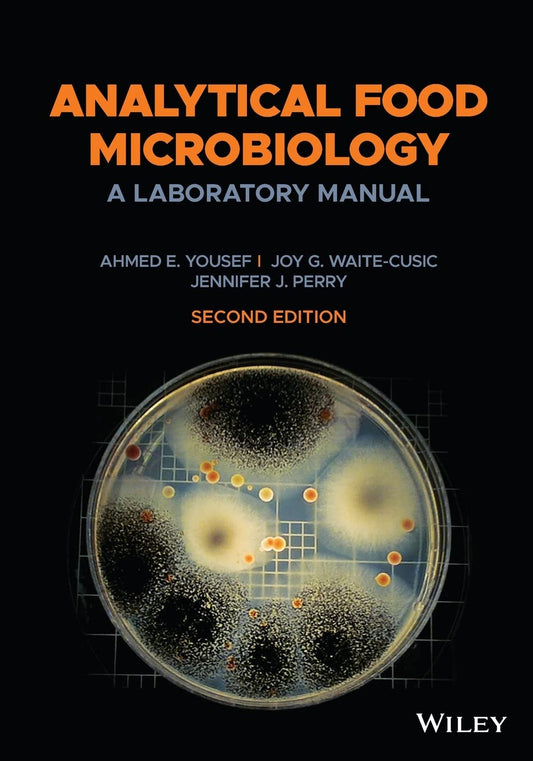
ANALYTICAL FOOD MICROBIOLOGY: A LABORATORY MANUAL

Collection: Products
-
Analytical Chemistry, An Indian Adaptation
Regular price £38.42 GBPRegular priceUnit price / per -
Analytical Chemistry: An Introduction
Regular price £23.97 GBPRegular priceUnit price / per -
Analytical Chemistry: Application Theory and Instrumentation
Regular price £59.93 GBPRegular priceUnit price / per -
ANALYTICAL FOOD MICROBIOLOGY: A LABORATORY MANUAL
Regular price £83.05 GBPRegular priceUnit price / per -
Analytical Index to Sir John W. Kaye's History of the Sepoy War, and Col. G.B. Malleson's History of the Indian Mutiny - Paperback
Regular price £24.97 GBPRegular priceUnit price / per -
Analytical Index to Sir John W. Kaye's History of the Sepoy War, and Col. G.B. Malleson's History of the Indian Mutiny - Hardcover
Regular price £27.86 GBPRegular priceUnit price / per -
Analytical Methods for Medicinal Plants and Economic Botany 2nd edn
Regular price £44.98 GBPRegular priceUnit price / per -
Analytical Methods in Combinatorial Chemistry
Regular price £53.26 GBPRegular priceUnit price / per -
Analytical Methods in Social Sciences Research
Regular price £42.98 GBPRegular priceUnit price / per -
Analytical Perspectives on the Indian Economy
Regular price £25.85 GBPRegular priceUnit price / per -
ANALYTICAL PROBLEMS IN CLASSICAL MECHANICS COMPLETE SOLUTIONS
Regular price £24.99 GBPRegular priceUnit price / per -
Analytical Procedures in Animal Nutrition and Feed Technology
Regular price £29.98 GBPRegular priceUnit price / per -
Analytical Techniques and Instrumental Methods in Soil, Plant and Water Analysis
Regular price £23.87 GBPRegular priceUnit price / per -
Analytical Techniques for Decision Making in Agriculture
Regular price £33.98 GBPRegular priceUnit price / per -
Analytical Techniques in Agriculture
Regular price £40.98 GBPRegular priceUnit price / per -
Analytical Techniques in Animal Nutrition
Regular price £41.98 GBPRegular priceUnit price / per -
Analytical Techniques in Animal Nutrition Research
Regular price £25.99 GBPRegular priceUnit price / per -
Analytical Techniques in DNA Sequencing
Regular price £22.01 GBPRegular priceUnit price / per -
ANALYZING COMPUTER SECURITY: A THREAT / VULNERABILITY / COUNTERMEASURE APPROACH
Regular price £35.96 GBPRegular priceUnit price / per -
ANALYZING MEMORY THE FORMATION, RETENTION, AND MEASUREMENT OF MEMORY
Regular price £71.48 GBPRegular priceUnit price / per -
ANALYZING NETWORK DATA IN BIOLOGY AND MEDICINE
Regular price £62.35 GBPRegular priceUnit price / per -
ANALYZING SOCIAL NARRATIVES
Regular price £50.98 GBPRegular priceUnit price / per -
ANANDA K. COOMAASWAMY`S WRITING ON GEOLOGY AND MINERALOGY: SCIENTIFIC PAPERS AND COMMENTS
Regular price £31.06 GBPRegular priceUnit price / per -
Ananda Ranga Pillai The ‘Pepys’ Of French India - HB
Regular price £44.88 GBPRegular priceUnit price / per -
Ananda Ranga Pillai The ‘Pepys’ Of French India - PB
Regular price £32.71 GBPRegular priceUnit price / per -
Anarchism -PB
Regular price £21.96 GBPRegular priceUnit price / per -
ANASTASIA SYNDROME, MARY HIGGINS CLARK
Regular price £15.01 GBPRegular priceUnit price / per -
Anatomic Basis of Neurologic Diagnosis 2nd Ed.
Regular price £130.64 GBPRegular priceUnit price / per -
Anatomy & Physiology (includes A&P Online course)-11E
Regular price £143.96 GBPRegular priceUnit price / per -
ANATOMY & PHYSIOLOGY LABORATORY MANUAL AND E-LABS: 11ST EDITION
Regular price £108.09 GBPRegular priceUnit price / per -
ANATOMY & PHYSIOLOGY: THE UNITY OF FORM AND FUNCTION
Regular price £51.04 GBPRegular priceUnit price / per -
ANATOMY COLORING BOOK WITH 450+ REALISTIC MEDICAL ILLUSTRATIONS WITH QUIZZES FOR EACH, STEPHANIE MCCANN
Regular price £36.98 GBPRegular priceUnit price / per -
Anatomy Diseases and Treatment of Domestic Animals
Regular price £50.99 GBPRegular priceUnit price / per -
Anatomy Made Easy - 1E
Regular price £24.89 GBPRegular priceUnit price / per -
Anatomy Of Comparative Vertebrates
Regular price £65.97 GBPRegular priceUnit price / per